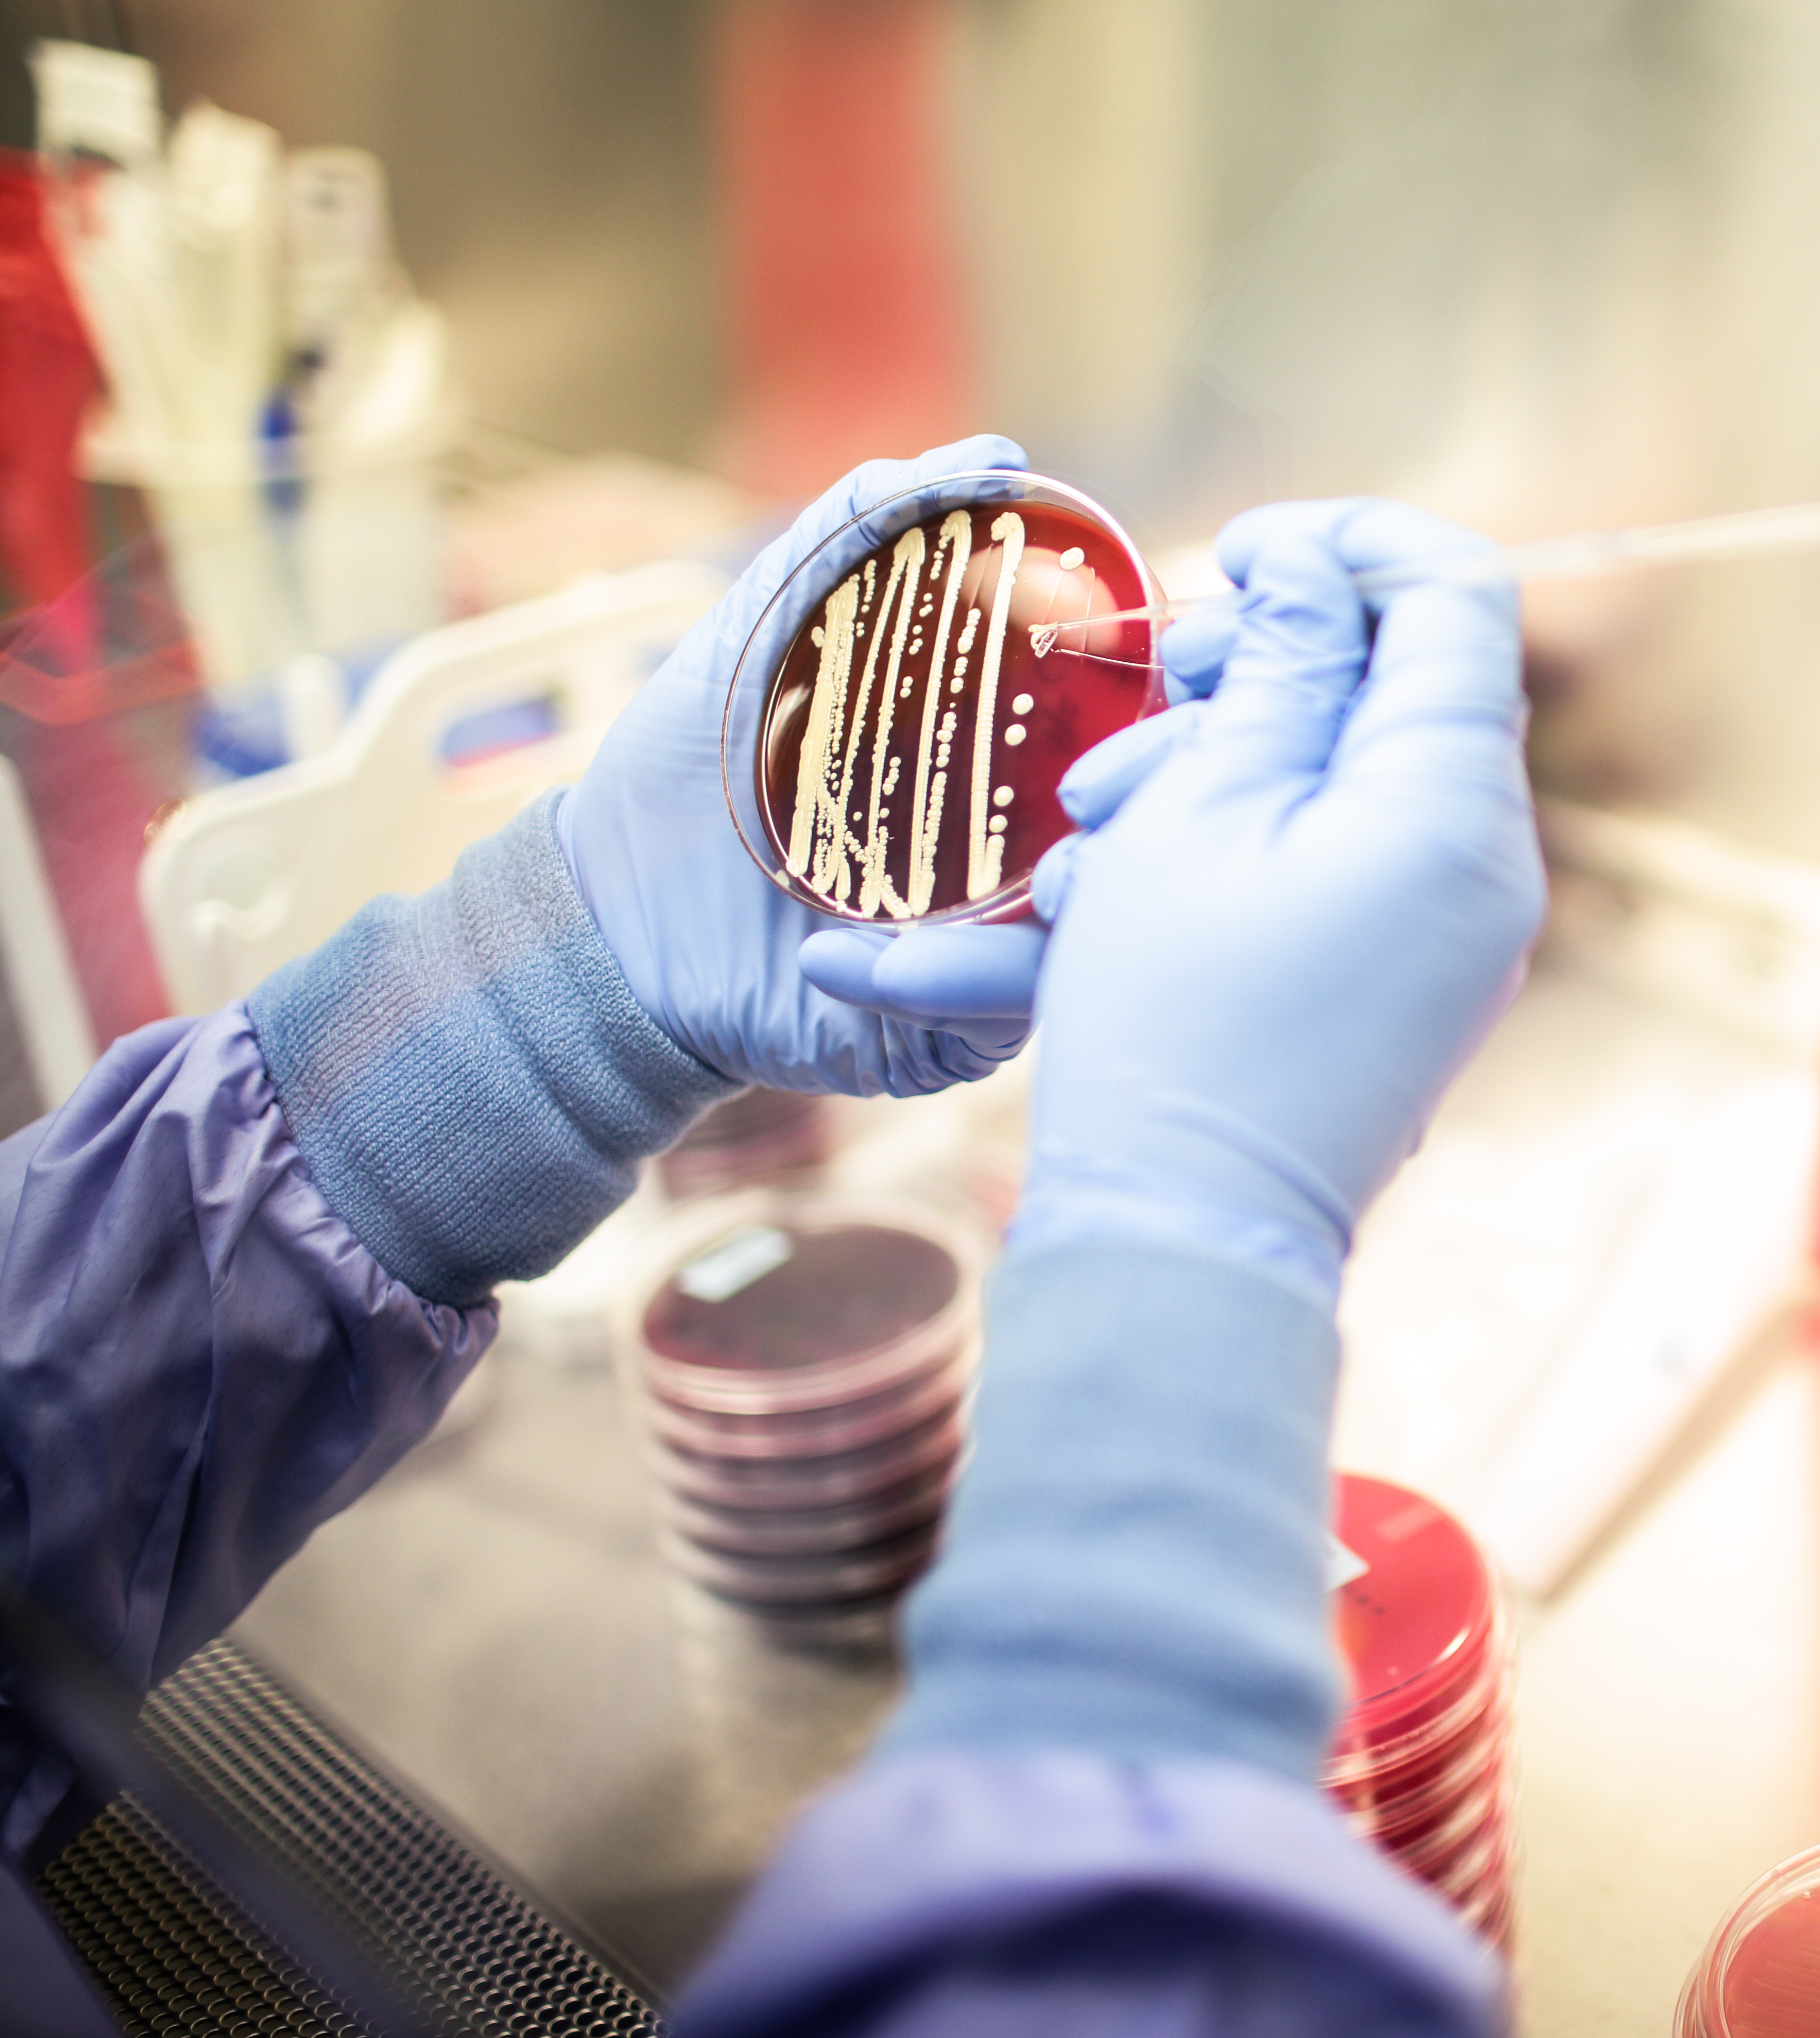
Scientist evaluating microbial identification and strain differentiation test results on agar plate
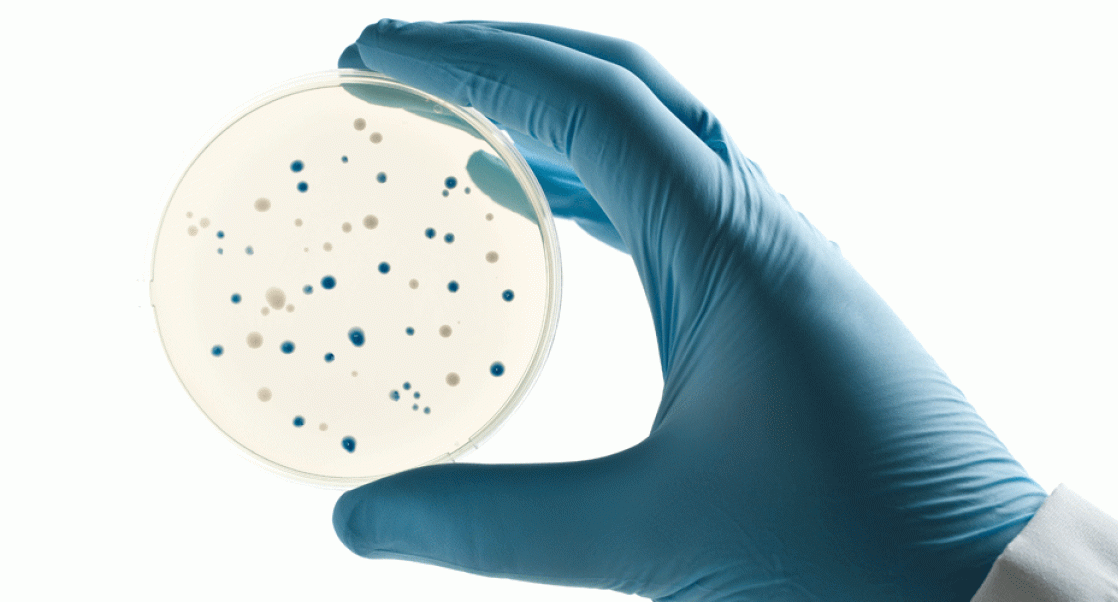
Lab worker holding a petri dish. Illustrates story about EMPQ mandates

Microbial Solutions
|
Nailing Down the Microbes
Four tips for choosing the best platform for identifying and characterizing the bugs that are lurking in your facilities
It’s common for microbes to turn up in a pharmaceutical or medical device facility, and understanding the who, what, where and why is a real high-tech game of sleuthing. Yet unlike all those detective shows, where the forensic scientists solve the case in, well, 60 minutes, properly identifying the offending microbe takes time and effort.
There are varied levels of operational needs and these needs dictate different approaches to microbial identification and strain differentiation. A technology must be suitable for the intended purpose. The limitations and strengths of the different technologies must be understood in order to choose the most appropriate method for the desired application. Closely related species may be difficult or impossible to distinguish using certain systems. In some cases, the most appropriate methods can vary based on the species under examination. Phenotypic systems use expressed gene products, including biochemical observations, to differentiate organisms. Proteotypic systems evaluate the physical characteristics of cellular proteins using matrix assisted laser desorption-ionization time-of-flight mass spectrometry (MALDI-TOF MS) for an identification. Genotypic systems use a phylogenetic sequence-based analysis for an identification. Having access to methods with different resolution allows for greater accuracy when there are clear expectations for each technology. Here are four considerations in choosing an appropriate identification or strain typing platform:
and strain differentiation. A technology must be suitable for the intended purpose. The limitations and strengths of the different technologies must be understood in order to choose the most appropriate method for the desired application. Closely related species may be difficult or impossible to distinguish using certain systems. In some cases, the most appropriate methods can vary based on the species under examination. Phenotypic systems use expressed gene products, including biochemical observations, to differentiate organisms. Proteotypic systems evaluate the physical characteristics of cellular proteins using matrix assisted laser desorption-ionization time-of-flight mass spectrometry (MALDI-TOF MS) for an identification. Genotypic systems use a phylogenetic sequence-based analysis for an identification. Having access to methods with different resolution allows for greater accuracy when there are clear expectations for each technology. Here are four considerations in choosing an appropriate identification or strain typing platform:
- Determine the level of resolution needed. A system that generates a genus and species designation is providing a microbial identification. A different system or technology will be needed for a strain-level comparison. Common platforms for microbial identification include phenotypic commercial systems and MALDI-TOF. These systems should only be used to generate an identification. If using phenotypic systems, confidence to the genus-level should be considered, while MALDI-TOF provides a confident species-level identification. Highly confident and accurate resolution at the species or strain level can be achieved through sequence-based approaches. The target gene will dictate the level of resolution. Strain-level differentiation can also be achieved through different fragment-based approaches. Accurate and consistent identification methods are critical in managing risk by yielding data that allow for comprehensive and reliable tracking and trending during routine monitoring. During an investigation, it is extremely important to be able to accurately identify organisms to the species level and distinguish between strains to complete the investigation. The priority of the samples will correlate with their criticality and will dictate which method should be used for the most accurate identification, and strain-level differentiation, of the microorganism.
- For identification, decide if the sample is for routine testing or a critical application. The identification of microorganisms can be done through different processes, each with its own level of accuracy and reproducibility. The methods chosen will impact the confidence in the data and decisions made based on those data. Routine identifications as part of an EM program provide useful information on the baseline picture of the normal microbiome and categorize the resident bioburden. Then if there is an excursion, determination whether the organism is normal, or novel can be done. Critical investigations into excursions, action limit overages or product failures require accurate identification to the species level and maybe strain characterization. Genotypic identification of bacteria and fungi has been shown with convincing scientific data to be the most accurate as it is based on highly conserved DNA sequences, and not effected by culture conditions or environmental factors. Sequence-based identification technologies should be used in critical situations, but can also be used for routine applications. MALDI-TOF is now shown to be a reliable method for identification of intact bacteria and yeast, and is more accurate than phenotypic systems, but not as accurate as sequence-based approaches. Thus, MALDI-TOF is ideal for fast, accurate routine identifications.
- If you are confirming the identity of a QC organism, make sure the technology you are using can resolve organisms in that genus. If the identity of the QC strain must be confirmed, it is imperative that the QA personnel ensure that the identification system being used has the correct species-level resolution for that organism. The capabilities of the technologies are not the same for different closely-related species and this must be understood before choosing an identification method, so that deviations and investigations can be avoided. For example, resolution of the Enterobacter cloacae complex is a challenge for MALDI-TOF. However, the species-level identification can be made with 16S rDNA sequencing and phylogenetic analysis. Sometimes, more than one species has the same or similar 16S rDNA sequence and thus cannot be resolved. This is true of the Burkholderia cepacia complex. Protein-coding genes, such as gyrB, rpoB, and recA, have a higher frequency of variations than the more conserved ribosomal gene regions. If the 16S rRNA genes are identical, differences can be seen in protein-coding genes and the species can be differentiated. Thus, if the species resolution of the identification platform is known, then the appropriate choice of a system can be made so that the expected identification matches the system output.
- Understand that not all strain typing systems are created equal. Increased discrimination or resolution at the strain level can be needed during investigations of sterility failures and other out-of-specification situations. Strain-level characterization of bacterial cultures can be provided by restriction fragment length polymorphisms. This system is based on the premise that the DNA restriction sites in the bacterial rRNA operon are conserved in some areas and are more variable in others. A strain differentiation is based on the DNA banding patterns. There can be issues with the data quality, such as uncut or partially cut DNA, that can interfere with the accuracy and repeatability of this method. Additional strain-level differentiation technologies involve PCR amplification of different DNA sequences to generate DNA barcodes. Taxa are differentiated by comparing the DNA banding patterns. All PCR-based technologies are dependent on DNA quality and consistent PCR temperatures for the reproducibility of the data. Multi-locus sequence typing (MLST) is a well-established, highly accurate sequence-based method for strain-level differentiation of bacteria and fungi. It analyzes sequence variations in multiple protein coding genes that contain a high degree of sequence variability. Depending on the degree of discrimination needed, strains can be evaluated by a different number of genes and these gene targets will differ from species to species. Strain comparison is made by evaluating the sequence type or allelic profile for the loci. Given the reproducibility and increased resolution of MLST, it is superior to fragment-based and PCR-based methods for determination of strain relatedness.
If you enjoyed this blog, check out Eureka's ongoing series by Accugenix scientists, MicroPhyles.